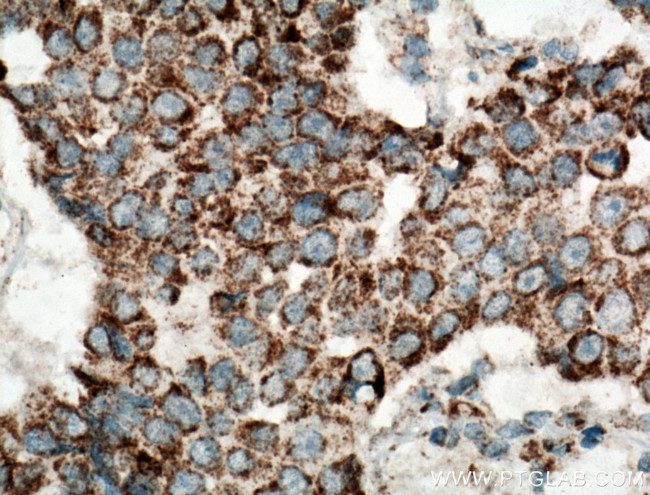
UQCRH Antibody in Immunohistochemistry (Paraffin) (IHC (P))

Search
Proteintech
UQCRH Polyclonal Antibody
{{$productOrderCtrl.translations['antibody.pdp.commerceCard.promotion.promotions']}}
{{$productOrderCtrl.translations['antibody.pdp.commerceCard.promotion.viewpromo']}}
{{$productOrderCtrl.translations['antibody.pdp.commerceCard.promotion.promocode']}}: {{promo.promoCode}} {{promo.promoTitle}} {{promo.promoDescription}}. {{$productOrderCtrl.translations['antibody.pdp.commerceCard.promotion.learnmore']}}
产品信息
12364-1-AP
种属反应
宿主/亚型
分类
类型
抗原
偶联物
形式
浓度
规格
纯化类型
保存液
内含物
保存条件
运输条件
产品详细信息
Immunogen sequence: MGLEDEQKM LTESGDPEEE EEEEEELVDP LTTVREQCEQ LEKCVKARER LELCDERVSS RSHTEEDCTE ELFDFLHARD HCVAHKLFNN LK (1-91 aa encoded by BC015177)
靶标信息
Cytochrome b-c1 complex subunit 6, mitochondrial is a protein that in humans is encoded by the UQCRHgene. This is a component of the ubiquinol-cytochrome c reductase complex (complex III or cytochrome b-c1 complex), which is part of the mitochondrial respiratory chain. This protein may mediate formation of the complex between cytochromes c and c1.
仅用于科研。不用于诊断过程。未经明确授权不得转售。
篇参考文献 (0)
生物信息学
蛋白别名: Complex III subunit 6; Complex III subunit VIII; Cytochrome b-c1 complex subunit 6, mitochondrial; Cytochrome c1 non-heme 11 kDa protein; cytochrome C1, nonheme 11 kDa protein; Mitochondrial hinge protein; mitochondrial hinge protein precursor; ubiquinol cytochrome c reductase hinge protein; Ubiquinol-cytochrome c reductase complex 11 kDa protein; ubiquinol-cytochrome c reductase, complex III subunit VIII; unnamed protein product
基因别名: 2210416J04Rik; 2310021J10Rik; 2610041P16Rik; MC3DN11; QCR6; UQCR8; UQCRH
UniProt ID: (Human) P07919, (Mouse) P99028, (Rat) Q5M9I5
Entrez Gene ID: (Human) 7388, (Mouse) 66576, (Rat) 366448